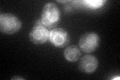
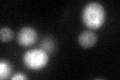

View description
Subunit c'' of the vacuolar ATPase, which functions in acidification of the vacuole; one of three proteolipid subunits of the V0 domain
Localization:
Intensity:
Fold change:
Significance:
-
C’ GFP library in SD
ER67.95 -
N' NOP1pr-GFP in SD

N/A0 -
N' TEF2pr-mCherry in SD

N/A0 -
N' NATIVEpr-GFP in SD

N/A0 -
N' TEF2pr-VC and Cyto-VN in SD

N/A0 -
C’ GFP library in SD+DTT
ER40.610.59Yes -
C’ GFP library in SD+H2O2

vacuoleN/AN/ANo -
C’ GFP library in Starvation Media

vacuoleN/AN/AYes -
C’ GFP library on the background of Pup2-DaMP

ER -
C’ GFP library on the background of CCT mutant

ER28.81970.424061Yes
